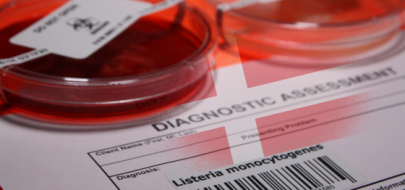

Litewski NVSC poinformował o dwóch podejrzeniach botulizmu po spożyciu suszonej płotki kupionej na targowisku w Wilnie. Kontrola VMVT ujawniła uchybienia dotyczące higieny, przechowywania i identyfikowalności, a pobrane próbki ryb badane są pod kątem obecności Clostridium botulinum. Choć botulizm na Litwie występuje rzadko, przypadki te zwracają uwagę na znaczenie prawidłowych praktyk technologicznych oraz wysokich standardów nadzoru – które Litwa wzmacnia również na poziomie międzynarodowym, koordynując unijny projekt wsparcia systemu bezpieczeństwa żywności w Serbii.
Systemowe wyzwania w nadzorze Campylobacter w świetle dwóch ognisk w Danii
W drugiej połowie 2025 roku w Danii odnotowano dwa równoległe ogniska zakażeń Campylobacter jejuni powiązane z krajowym mięsem drobiowym. Wyróżniały się one nietypowo ciężkim przebiegiem klinicznym, w tym wysokim odsetkiem hospitalizacji i bakteriemii.
Charakterystyka i skala ognisk
Od lipca do października 2025 roku duński system nadzoru, wykorzystujący sekwencjonowanie całogenomowe (WGS), wykrył dwa jednoczesne ogniska wywołane przez szczepy Campylobacter jejuni oznaczone jako ST49#3 oraz ST52#4. Łącznie zgłoszono 112 przypadków (odpowiednio 83 i 29 dla poszczególnych wariantów), jednak naukowcy oszacowali rzeczywistą liczbę laboratoryjnie potwierdzonych zakażeń na około 900 (670 w pierwszym ognisku i 238 w drugim). Ogniska te miały zasięg ogólnokrajowy. Wywiady przeprowadzone z pacjentami wykazały, że 100% ankietowanych spożywało mięso z kurczaka w tygodniu poprzedzającym wystąpienie objawów.
Przebieg kliniczny i inwazyjność
Zgromadzone dane wskazują na znaczną wirulencję wykrytych szczepów, co podważa postrzeganie kampylobakteriozy jako choroby łagodnej i samoograniczającej się. Odnotowano wysokie wskaźniki ciężkiego przebiegu klinicznego:
Hospitalizacja: Wymagało jej 45 pacjentów (40%). Dla porównania, w 2024 roku ogólny odsetek hospitalizacji z powodu kampylobakteriozy w Danii wynosił 16%. W przypadku wariantu ST52#4 hospitalizowano aż 52% zakażonych.
Bakteriemia: Obecność bakterii we krwi stwierdzono u 16 osób (14%), przy czym dla wariantu ST49#3 odsetek ten wyniósł 18%. Jest to wartość znacząco przekraczająca duński poziom bazowy dla bakteriemii Campylobacter, który wynosi poniżej 0,5%.
Zakażenia odnotowano w szerokim przedziale wiekowym – od 2 do 90 lat – a ciężki przebieg choroby występował w różnych grupach wiekowych, nie ograniczając się wyłącznie do osób starszych.
Źródło zakażenia i profil mikrobiologiczny
Analiza genetyczna potwierdziła, że izolaty pobrane od pacjentów były tożsame z bakteriami wykrytymi w tym samym czasie w mięsie drobiowym produkowanym w Danii. Oba warianty (ST49#3 i ST52#4) były już wcześniej wykrywane w poprzednich latach zarówno u pacjentów, jak i w duńskim drobiu. Badania wykazały obecność mutacji gyrA T86I w obu szczepach, co oznacza ich przewidywaną oporność na ciprofloksacynę i kwas nalidiksowy (fluorochinolony).
Kontekst regulacyjny i wnioski badaczy
Ogniska wystąpiły w okresie obowiązywania nowych przepisów UE, które weszły w życie w styczniu 2025 roku. Zgodnie z nimi, w badanej partii 50 próbek tusz nie więcej niż 10 może przekroczyć poziom zanieczyszczenia 1 000 jtk/g. Przekroczenie tego limitu wymaga poprawy higieny uboju, rewizji kontroli procesu oraz środków biosekuracji na fermach.
Autorzy badania opublikowanego w Eurosurveillance wskazują, że wystąpienie tak dużych i ciężkich ognisk ujawnia luki w obecnym systemie prewencji, opartym na kryteriach higieny procesu, a nie na kryteriach bezpieczeństwa żywności. Obecny stan prawny nie zakazuje wprowadzania do obrotu świeżego mięsa drobiowego z obecnością Campylobacter, co w praktyce przenosi ciężar ograniczania ryzyka na konsumentów i ich praktyki higieniczne w kuchni.
Źródło: Eurosurveillance
Przeczytaj także
-
 04.12.2025
04.12.2025
Co nowego w bazie CHEFS? Trendy, metody kontroli i źródła niezgodności w europejskiej żywności
Czytaj więcejBaza CHEFS dostarcza najobszerniejszych danych o bezpieczeństwie żywności w Europie. Najnowsza analiza ujawnia, które substancje są monitorowane najczęściej, jak różnią się strategie poboru próbek między państwami oraz z jakich kierunków importowych napływa najwięcej produktów z przekroczeniami norm. To nowe spojrzenie na znane już narzędzie — z perspektywy danych, które do tej pory pozostawały w cieniu.
-
 01.12.2025
01.12.2025
Podejrzenia botulizmu po spożyciu suszonej ryby na Litwie
Czytaj więcej -
25.11.2025
25.11.2025
Nowe ognisko Listeria monocytogenes w Danii: siedem zakażeń potwierdzonych przez SSI
Czytaj więcejW Danii potwierdzono ognisko zakażeń Listeria monocytogenes o typie sekwencyjnym 403. Od sierpnia 2025 r. odnotowano siedem przypadków, a duńskie instytucje zdrowia publicznego prowadzą wspólne dochodzenie nad ustaleniem źródła zakażenia.













.png)
.png)
